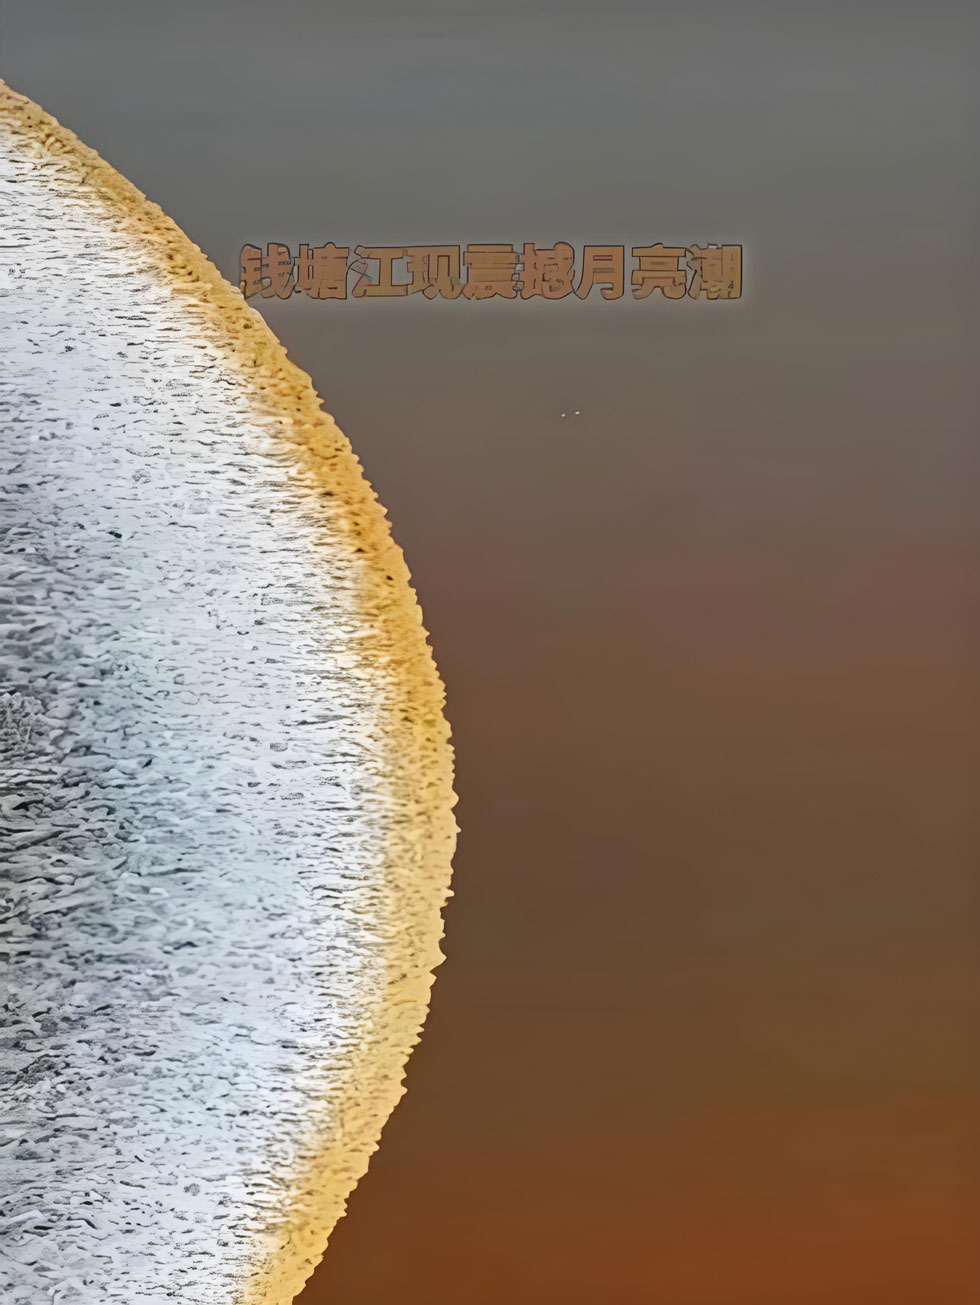
中秋钱塘江月亮潮.jpg

中秋钱塘江月亮潮震撼来袭!海宁盐官一线潮观潮全攻略,假期必打卡
中秋钱塘江月亮潮震撼来袭! 今年农历八月十八前后,钱塘江大潮与中秋明月相遇,将上演"月潮共舞"的绝美景致。海宁盐官一线潮观潮全攻略在此为您奉上,这份假期必打卡的指南将带您领略天下第一潮的壮阔,并提供实用的游览建议。
观潮亮点:月亮潮与一线潮
什么是"月亮潮"
① 奇特形态:钱塘江近日涌现罕见的"月亮潮"奇观,圆弧形潮头翻卷白浪,形似巨大白玉盘倾泻而下。
② 形成原理:这种特殊潮形需要天文、地理、气象三重条件完美配合。当潮水经过特定河段时,会产生反射波,与后续潮头碰撞后形成稳定弧形。
盐官一线潮
① 经典景观:在江道顺直且没有障碍物的区域,会形成一条线状的整齐潮头,即著名的"一线潮",潮水从远方笔直涌来,像白色城墙压向岸边。
② 最佳观赏点:海宁盐官观潮胜地公园是观赏一线潮的最佳地点,这里还能看到潮水与400年历史的占鳌塔同框的经典画面。
️ 最佳观潮时间
观潮季节
① 年度最佳:每年农历八月十八前后是钱塘江大潮最为壮观的时期。
② 月度周期:每月农历初一至初六、十五至二十均为钱塘江大潮日。
每日潮时
① 查询工具:潮水每天到达时间不同,受风力、江水流量等因素影响,实际到达时间可能有约20分钟的浮动。
② 实时查询:可通过"浙里办"APP搜索"潮来了",或关注"浙江水利"微信公众号,在菜单栏中选择【便民互动】-【潮汐预报】,查看每日潮汛时间和观潮指数。
️ 盐官观潮全攻略
观潮点位推荐
盐官观潮胜地公园:这里是观赏"一线潮"最经典的地点。
① 最佳机位:2号观潮台(景区中间位置,视野无遮挡)、白石台广场(能拍潮水撞石塘的瞬间)。
② 隐藏打卡:景区里有巨型《观潮》语文书雕塑,拍复古大片超有氛围感。
其他特色观潮点:
① 萧山美女坝:可观回头潮与冲天潮,潮水撞坝后猛地折返,形成高达数米的"回头潮"。
② 海宁新仓梁家墩:可观赏"交叉潮",潮水分成两股交会成"十字潮",人比盐官少,能轻松拍摄。
交通指南
1. 自驾路线
① 前往盐官:从杭浦高速盐官出口下高速的观潮车辆可以直接进入专用匝道直达1号停车场停车,匝道实行单向通行。
② 停车信息:盐官景区有多个停车场,使用百度地图、高德地图可直接导航至停车场。
2. 公共交通
城铁+公交:可乘坐杭海城铁到盐官站,转332路公交直达;观潮活动期间,除常规公交线路外,将增开城铁观潮专线。
3. 交通限行提示
① 国庆限行:10月6日至10月11日,海宁观潮景区及周边道路实施临时交通限行措施。
② 单双号限行:10月8日至10月9日(农历八月十七至十八),在海宁丁桥和盐官两个观潮区域内,嘉兴籍(浙F号牌)小型微型客车实行单双号限行。
费用与票务
① 盐官观潮胜地公园门票:10月5-13日观潮季90元/人,淡季30元/人。
② 免费观潮点:萧山美女坝、海宁新仓梁家墩、西湖九溪等观潮点免费。
拍照与观潮技巧
最佳拍摄建议
① 黄金时段:拍摄月亮潮需把握两个黄金时段——盐官段11:30-12:30潮头形态最完整,曹娥江段13:00-14:00则能捕捉到多潮叠加的壮观景象。
② 拍摄技巧:选择能见度高的上午观测,并使用高速连拍模式记录转瞬即逝的完美弧线。
穿搭与装备
① 穿搭建议:卡其色/黑色外套(拍潮水反差大,显白出片)、棒球帽(挡风又上镜)。
② 必备装备:手机防水袋(浪花飞溅防进水)、充电宝(拍视频超耗电)、折叠小板凳(排队占位神器)。
⚠️ 安全须知
钱塘江潮水威力巨大,观潮时务必注意安全:
① 保持安全距离:要选择安全区域和地段,注意观潮区域的警示标志,服从管理人员的管理。
② 远离危险区域:不要翻越挡墙到江滩、丁字坝等危险区域观潮、玩耍。
③ 特别警惕:避开弯道的潮流下方,这种地方潮水往往蹿上塘来,躲闪不及。
④ 遇险应对:一旦遇险不要慌张,应及时呼救并迅速有序向安全地带撤退。
️ 周边游览与住宿
盐官古城游玩
盐官古城不仅是观潮胜地,还有丰富的历史文化景点:
① 海神庙:"江南小故宫",雍正御碑、汉白玉石狮霸气十足。
② 金庸书院:展示金庸生平与作品,院内有"江湖"主题展区。
③ 陈阁老宅:清代宰相陈元龙府邸,传与乾隆身世之谜相关。
住宿推荐
① 主唱音乐度假酒店:位置便利,地处盐官潮乐之城C位,酒店内布满音乐元素。
② 盐官开元观堂:古风酒店,近观潮点。
贴心提示
1. 提前抵达:热门点位提前1-2小时到,国庆人多,晚到只能看人头。
2. 勿信"私人观潮位":路边拉客的"最佳点位"多是陷阱,不仅花钱还危险。
3. 注意天气:观潮前要及时关注天气预报和钱塘江潮汐预报。
4. 错峰观潮:国庆期间人流量大,如可能,考虑错峰出行,获得更好体验。
中秋月圆时,潮水如约至。这份攻略希望能帮助您在钱塘江畔度过一个安全而难忘的观潮假期。无论是那震撼的一线潮、罕见的月亮潮,还是盐官古城的文化韵味,都将成为您金秋假期最独特的记忆。祝您观潮愉快!